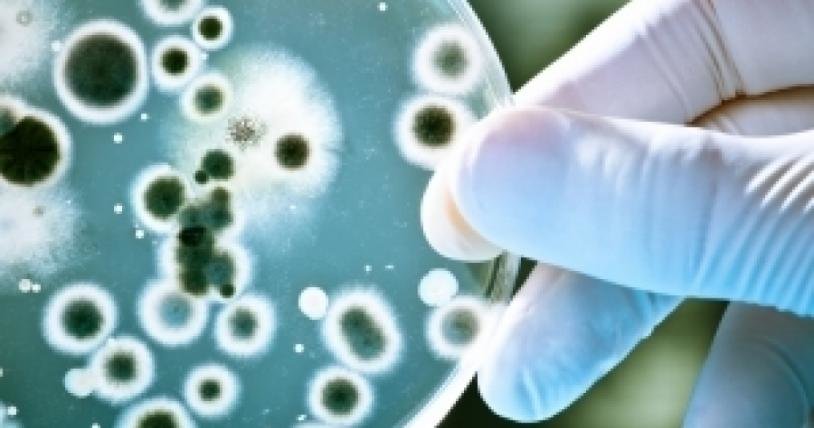
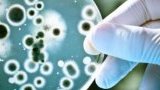

Младежите от ЦНСТ "Любов" с бактериална инфекция, състоянието им е добро
11:59, 24 юни 16
25
676
Шрифт:
Изследванията показват, че става дума за бактериална инфекция, причинена от бактерията Стафилококус ауреус (Staphylococcus aureus), известна още като златист стафилокок. Тя най-вероятно е приета чрез храна.
На шестимата пациенти са направени антибиограми, като към момента инфекцията е овладяна и състоянието им е добро.

Добави коментар